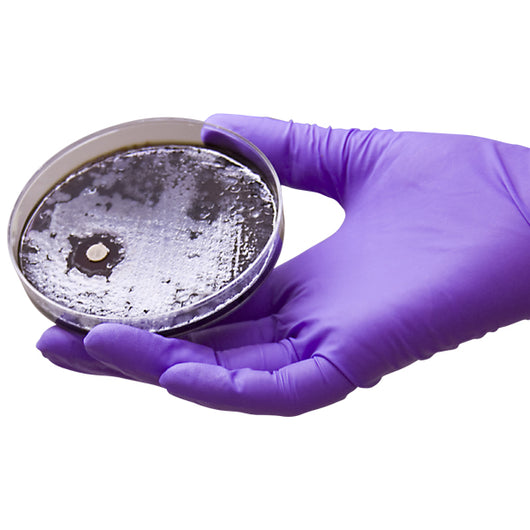
Nitrile Glove Range

Excellent dexterity | Excellent stretch | Excellent strength
Core Specifications
Colours
Blue
Green
Pink
Purple
White
Product Details
Features
- Ambidextrous
- Disposable
- Powder free
- Latex free
- Excellent dexterity
- Excellent stretch
- Excellent strength
Sizes
Small
Medium
Large
Extra Large
Double Extra Large
Minimum Order
1 Carton
Certifications
Please request a data sheet on the gloves that you require. Certifications and specifications will differ from one product to another. The vast majority of Nitrile gloves that Harcor supply are HACCP certified and listed with TGA.